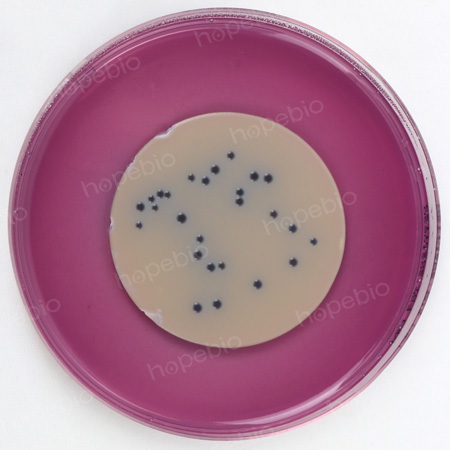

海博微信公众号
海博微信公众号
 海博天猫旗舰店
海博天猫旗舰店


 海博微信公众号
海博微信公众号
 海博天猫旗舰店
海博天猫旗舰店




引言
微生物监测是评估近岸河流水环境质量的重要环节,污水中常含有一定数量的病原微生物,是引发水传播疾病的重要来源。其中较为常见且具有重要影响的包括:沙门氏菌属、志贺氏菌属、粪链球菌、肠道病原性大肠埃希氏菌以及肠道病毒等。前文已简述沙门氏菌属、总大肠菌群的测定方法,本文将继续以《水和废水监测分析方法(第四版)》为参考依据,系统阐述粪大肠菌群的测定方法与流程,旨在为实际监测工作提供参考。
对于其他近岸河流水微生物检测的相关内容可参考《近岸河流水域微生物检测-沙门氏菌属的测定》、《近岸河流水域微生物检测-总大肠菌群的测定多管发酵法》等文章。
一、粪大肠菌群
总大肠菌群是指那些能在37℃48 h之内发酵乳糖产酸产气的、需氧及兼性厌氧的革兰氏阴性的无芽孢杆菌。上要包括有埃希氏菌属、柠檬酸杆菌属、肠杆菌属、克雷伯氏菌属等菌属的细菌。
粪大肠菌群是总大肠菌群中的一部分,主要来自粪便。在44.5℃温度下能生长并发酵乳糖产酸产气的大肠菌群称为粪大肠菌群。用提高培养温度的方法,造成不利于来自自然环境的大肠菌群生长的条件,使培养出来的菌主要为来自粪便中的大肠菌群,从而更准确地反映出水质受粪便污染的情况。
二、粪大肠菌群的测定
粪大肠菌群的测定主要为多管发酵法和滤膜法。
(一)多管发酵法
多管发酵法是根据大肠菌群细菌能发酵乳糖、产酸产气以及具备革兰氏染色阴性、无芽孢、呈杆状等有关特性,主要区别时通过初发酵试验后,能够在EC肉汤中以44.5℃温度培养后生长并产气。
1.培养基
(1)乳糖蛋白胨培养液HB0119乳糖蛋白胨培养液
(2)三倍浓度乳糖蛋白胨培养液HBPT009-3乳糖糖蛋白胨培养液管(3倍)
(3)EC肉汤培养基EC肉汤(GB4789.38-2025)
2.步骤
(1)水样接种量
将水样充分混匀后,根据水样污染的程度确定水样接种量。每个样品至少用三个不同的水样量接种。同一接种水样量需五管。
相对未受污染的水样接种量为10 mL、1 mL、0.1 mL。受污染水样接种量根据污染程度接种1 mL、0.1 mL、0.01 mL或0.1 mL、0.01 mL、0.001 mL等(见表1)。
如接种体积为10 mL,则试管内应装有三倍浓度乳糖蛋白胨培养液5 mL;如接种量为1 mL或少于1 mL,则可接种于普通浓度的乳糖蛋白胨培养液10 mL中。
表1多管发酵法接种用水量参考表
|
水样种类 |
接种量(mL) |
||||||
|
10 |
1 |
0.1 |
10-2 |
10-3 |
10-4 |
10-5 |
|
|
较清洁的湖水、井水 |
√ |
√ |
√ |
|
|
|
|
|
一般的江、河、塘水 |
|
√ |
√ |
√ |
|
|
|
|
城市内的河、湖、塘水 |
|
|
|
√ |
√ |
√ |
|
|
城市原污水 |
|
|
|
|
√ |
√ |
√ |
(2)初发酵试验
将水样分别接种到盛有乳糖蛋白胨培养液的发酵管中。在37℃±0.5℃下培养24 h±2 h。产酸和产气的发酵管表明试验阳性。如在倒管内产气不明显,可轻拍试管,有小气泡升起的为阳性。如图1。

图1乳糖蛋白胨培养液发酵管的特征(左2为只产酸,右2为产酸产气)
(3)复发酵试验
轻微振荡初发酵试验阳性结果的发酵管,用3 mm接种环或灭菌棒将培养物转接到EC培养液中。在44.5℃±0.5℃温度下培养24 h±2 h(若使用水浴箱,则水面应高于试管中培养基液面)。
接种后所有发酵管必须在30 min内放进恒温培养箱或水浴相中。培养后立即观察,发酵管产气则证实为粪大肠菌群阳性。
3.计算和报告结果
根据不同接种量的发酵管所出现阳性结果的数目,从MPN表中查得相应的MPN指数,按总大肠菌群的计算方法计算每升水中粪大肠菌群细菌的MPN值。
(二)滤膜法
同总大肠菌群一样,粪大肠菌群的密度也可用滤膜技术来测定。
1.培养基
MFC培养基HB0154MFC琼脂
2.步骤
(1)水样过滤
①水样量的选择:水样量的选择根据细菌受检验的特征和水样中预测的细菌密度而定。
如未知水样中粪大肠菌的密度,就应按下表所列体积过滤水样,以得知水样的粪大肠菌的密度,先估计出适合在滤膜上计数所应使用的体积,然后再取这个体积的1/10和10倍,分别过滤。理想的水样体积是一片滤膜上生长20 CFU~60 CFU粪大肠菌群菌落,总菌落数不得超过200 CFU。使用的水样量可参考表2。
表2滤膜法接种用水量参考表
|
水样种类 |
接种量(mL) |
||||||
|
100 |
50 |
10 |
1 |
0.1 |
10-2 |
10-3 |
|
|
较清洁的湖水、井水 |
√ |
√ |
√ |
|
|
|
|
|
一般的江、河、塘水 |
|
√ |
√ |
√ |
|
|
|
|
城市内的河、湖、塘水 |
|
|
|
√ |
√ |
√ |
|
|
城市原污水 |
|
|
|
|
√ |
√ |
√ |
②水样的过滤:按总大肠菌群滤膜法水样过滤的步骤和注意事项进行过滤,详情参考《近岸河流水域微生物检测-总大肠菌群的测定滤膜法》。
(2)培养
使用MFC培养基。将滤过水样的滤膜置于琼脂或含有MFC液体培养基的吸收垫表面。将培养皿紧密盖好后,置于44.5℃±0.5℃的恒温培养箱或恒温水浴中,经24 h±2 h培养。若用恒温水浴培养,则保证培养皿经过密封处理后完全浸没于44.5℃±0.5℃恒温水浴中。所有已制备的培养物都应在过滤后30 min内进行44.5℃培养。
3.计算及报告结果
粪大肠菌群菌落在MFC培养基上呈蓝色或蓝绿色,其他非粪大肠菌群菌落呈灰色、淡黄色或无色。正常情况下,由于温度和玫瑰酸盐试剂的选择性作用,在MFC培养基上很少见到非粪大肠菌菌落。必要时可将可疑菌落接种于EC培养液,44.5℃±0.5℃培养24 h±2 h,如产气则证实为粪大肠菌群。
图2粪大肠菌群在MFC琼脂培养基
计数呈蓝或蓝绿色的菌落,计算出每1 L水样中的粪大肠菌群数。

三、相关培养基的采购
九州登录网页中国有限公司有适用于水中粪大肠菌群检验的相关培养基,客户可根据实际情况和用途进行选用。
|
产品编号 |
产品名称 |
规格 |
产品说明及用途 |
|
HB0119 |
250g |
用于饮用水,水源水中大肠菌群的测定 |
|
|
HBPT009-3 |
5ml*20支/盒 |
用于微生物培养 |
|
|
HB0105 |
250g |
用于粪大肠菌群、大肠杆菌的测定 |
|
|
HB0154 |
250g |
用于生活饮用水及其水源水中粪大肠菌群测定 |
注:本文属海博生物原创,未经允许不得转载。
下一篇:没有了!
| 相关文章: | ||



